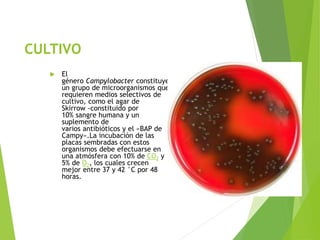
CULTIVO
 El
género Campylobacter constituye
un grupo de microorganismos que
requieren medios selectivos de
cultivo, como el agar de
Skirrow -constituido por
10% sangre humana y un
suplemento de
varios antibióticos y el «BAP de
Campy».La incubación de las
placas sembradas con estos
organismos debe efectuarse en
una atmósfera con 10% de CO2 y
5% de O2, los cuales crecen
mejor entre 37 y 42 °C por 48
horas.

La bacteria Campylobacter es un género de bacterias Gram negativas con forma de coma que se encuentra comúnmente en animales. Se cultiva mejor a temperaturas entre 37-42°C en medios selectivos. Las infecciones por Campylobacter causan diarrea, fiebre y dolor abdominal durante 2-5 días y rara vez pueden producir complicaciones como artritis reactiva.